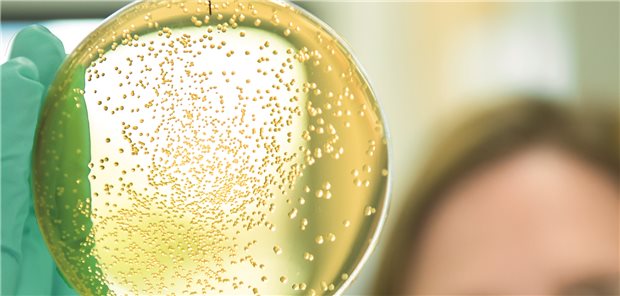
„Forschung ist Teil unserer DNA“ – Onkologische Erkrankungen und Virusinfektionen im Fokus „Forschung ist Teil unserer DNA“ – Onkologische Erkrankungen und Virusinfektionen im Fokus

Themenseite Hepatitis A/B/C...
Themenseite - Hepatitis A/B/C...
Xenotransplantation
Erstmals genetisch modifizierte Schweineleber in lebenden Menschen transplantiert
Hepatozelluläres Karzinom
Leberkrebs: Screening nach ausgeheilter Hepatitis C bald personalisiert
09.10.2025
|
Xenotransplantation
Erstmals genetisch modifizierte Schweineleber in lebenden Menschen transplantiert
26.09.2025
|
Hepatozelluläres Karzinom
Leberkrebs: Screening nach ausgeheilter Hepatitis C bald personalisiert
09.09.2025
|
Strategiepapier vorgelegt
Lancet-Kommission: Mehr als jeder zweite Leberkrebs kann verhindert werden
08.08.2025
|
Und bei weiteren Risikogruppen
Infektiongeschehen bei Betroffenen von Wohnungslosigkeit: gehäuftes Auftreten von Diphtherie-Fällen
Meinung